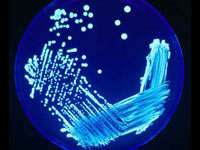

|
Éxitos transgénicos: la insulina
 Lunes, 16/1/2012 - 9:46
Lunes, 16/1/2012 - 9:46
Por Vicente Planelles
Desde su descubrimiento, la insulina se ha convertido en una de las moléculas más estudiadas de la historia de la medicina. Como todos sabemos, la insulina es una proteÃna relacionada con la diabetes, una enfermedad que afecta a un amplio porcentaje de la población.
Leer más...
|
|
Los genes de la longevidad mueren muy jóvenes
 Miércoles, 19/10/2011 - 14:11
Miércoles, 19/10/2011 - 14:11
Por Vicente Planelles
Desde su descubrimiento, la insulina se ha convertido en una de las moléculas más estudiadas de la historia de la medicina. Como todos sabemos, la insulina es una proteÃna relacionada con la diabetes, una enfermedad que afecta a un amplio porcentaje de la población.
Leer más...
|
|
De la revolución verde a la revolución transgénica
 Domingo, 22/8/2010 - 22:32
Domingo, 22/8/2010 - 22:32
Por Daniel RodrÃguez Herrera
La oposición ecologista a los transgénicos es elitista y conservadora. Las crÃticas vienen, como siempre, de los sectores más privilegiados: los que viven en la comodidad de las sociedades occidentales, los que no han conocido de cerca las hambrunas.
Leer más...
|
|
La eugenesia plantea abrir un debate sobre el 'mejoramiento' humano
 Lunes, 12/4/2010 - 0:19
Lunes, 12/4/2010 - 0:19
Por Javier Leo/Cristina Sánchez
Como si de una actualización de «software» se tratase, las manipulaciones genéticas permitirÃan reprogramar al hombre para que necesitase dormir y comer menos y pudiera nacer sin predisposiciones a determinadas enfermedades.
Leer más...
|
|
En 2 barriles vivían cepas Milenarias
 Domingo, 5/4/2009 - 13:33
Domingo, 5/4/2009 - 13:33
Un grupo de biólogos de la Universidad Católica revivió cepas de levadura halladas en barriles que datan de 1566. Un joyero ayudó en la recuperación.
Leer más...
|
|
Transgénicos que salvan vidas
 Viernes, 6/3/2009 - 16:52
Viernes, 6/3/2009 - 16:52
Por Esther Samper
En un clima de confusión global, los transgénicos se perciben, sin distinciones, como entes dañinos y malignos que vienen a perjudicar el mundo. Pocos son los que conocen que gracias a los transgénicos millones de personas han salvado sus vidas y pueden seguir viviendo.
Leer más...
|
|
Vida sintética: los animales y bacterias que poblarán el futuro
Jueves, 5/3/2009 - 15:34
Jueves, 5/3/2009 - 15:34
Por Sebastián Urbina
El primer paso fue crear un ADN inexistente de 12 bases, ocho más que el tradicional. Hoy se manipulan bacterias para producir medicamentos; luego vendrán insectos y animales hasta ahora desconocidos. ¿Al final?, crear vida superior.
Leer más...
|
|
|







